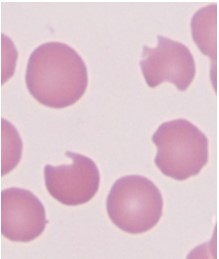
A 24-year-old man is evaluated for episodic anemia, jaundice, and dark urine.  These episodes typically occur after the use of certain drugs or following infection.  Additional history reveals that he has a brother who experiences similar episodes.  Peripheral blood smear reveals red blood cells with the findings shown below.   Deficiency of which of the following enzymes would most likely result in a condition similar to this patient's presentation? A) Bisphosphoglycerate mutase B) Glutathione reductase C) Hexokinase D) Pyruvate kinase E) Transketolase

A 24-year-old man is evaluated for episodic anemia, jaundice, and dark urine. These episodes typically occur after the use of certain drugs or following infection. Additional history reveals that he has a brother who experiences similar episodes. Peripheral blood smear reveals red blood cells with the findings shown below. Deficiency of which of the following enzymes would most likely result in a condition similar to this patient's presentation?
Deficiency of which of the following enzymes would most likely result in a condition similar to this patient's presentation?
A) Bisphosphoglycerate mutase
B) Glutathione reductase
C) Hexokinase
D) Pyruvate kinase
E) Transketolase
Correct Answer:
Verified
Q115: A 2-day-old boy is being examined in
Q116: A 22-year-old woman comes to the hospital
Q117: A 6-year-old African American boy is brought
Q118: A 48-year-old woman comes to the emergency
Q119: A 34-year-old man comes to the emergency
Q121: A 15-year-old boy is found to have
Q122: A 5-year-old boy is brought to the
Q123: A 22-year-old man comes to the office
Q124: A 6-year-old African American male is brought
Q125: A 17-year-old girl comes to the office
Unlock this Answer For Free Now!
View this answer and more for free by performing one of the following actions

Scan the QR code to install the App and get 2 free unlocks

Unlock quizzes for free by uploading documents